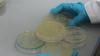
Японские ученые научились уничтожать раковую клетку

отметили
50
человек
в архиве
Россия хочет влиять на мировые цены на нефть
 vz.ru
vz.ru
Министр энергетики Сергей Шматко рассказал, что его ведомство разрабатывает политику, благодаря которой Россия сможет влиять на мировые цены на нефть. По его словам, роль РФ уже достаточно весома для этого.
«России необходимо активно заниматься вопросами влияния на уровень текущего рынка цен на ...
нет комментариев
отметили
57
человек
в архиве
В Грузии будет создан Музей российской агрессии
 apsny.ge
apsny.ge
В Грузии будет создан Музей российской агрессии. Об этом на заседании парламентского комитета по образованию и науке заявил сегодня министр культуры, спорта и охраны памятников Николоз Вачеишвили. По его словам, в такой музей будет переделан Дом-музей Сталина в городе Гори.
По его словам, д...
отметили
48
человек
в архиве
«Рамблер» запустил сервис бесплатного лицензионного видео
 internet.cnews.ru
internet.cnews.ru
Компания «Рамблер Медиа» объявила о запуске первого в России сайта бесплатного лицензионного видео «Рамблер Кинозал». Новый сервис предоставляет пользователям возможность бесплатно скачивать лицензионное видео высокого качества. На базе этого стартапа компания планирует в дальнейшем разработать моде...
проблема (1)
отметили
47
человек
в архиве
У Антарктики нашли защитный химический пояс
 lenta.ru
lenta.ru
Ученые обнаружили, что воздух Антарктики защищен от загрязнения специальным атмосферным барьером. Об этом сообщает журнал New Scientist.
Климатологам было известно, что воздушные потоки южного и северного полушария практически не смешиваются. Их разделяет так называемая внутритропическая зо...
отметили
40
человек
в архиве
Oracle выпускает собственные серверы
 cnews.ru
cnews.ru
Корпорация Oracle впервые за свою историю выходит на рынок аппаратного обеспечения. Первыми продуктами компании стали два продукта, разработанные совместно с HP. Используемый в них принцип параллельной обработки запросов позволяет решить главную проблему систем хранения данных (СХД) — значительно ув...
проблема (1)
отметили
62
человека
в архиве
Китай запускает третий пилотируемый космический корабль
 rian.ru
rian.ru
Китай запускает в четверг в космос свой третий пилотируемый корабль "Шэньчжоу-7", с борта которого состоится первый выход космонавта КНР в открытый космос, передает корреспондент РИА Новости.
Пуск состоится в промежутке между 21.07 и 22.27 по местному времени (17.07-18.27 мск).
...
отметили
55
человек
в архиве
Digg.com привлек инвестиции в размере 28,7 млн долларов
 cybersecurity.ru
cybersecurity.ru
Новостной сайт Digg.com привлек в новом раунде финансирования инвестиции в размере 28.7 млн долларов. Полученные деньги Digg намерен пустить на международную экспансию, а также на "противостояние трудным экономическим периодам для веб-бизнеса".
Глава Digg Inc Джей Аделсон рассказы...
отметили
30
человек
в архиве
Студенты и домохозяйки выведут на чистую воду недобросовестных торговцев Малайзии
 prian.ru
prian.ru
Власти Малайзии наняли 2 тыс. домохозяек и студентов для проведения «секретной» операции по выявлению розничных торговцев, которые устанавливают завышенные цены на свои товары и услуги.
По словам главы Министерства по вопросам потребителей и внутренней торговли Мохаммеда Рослана Махаюдина, ...
отметили
45
человек
в архиве
Слуцкер хочет снова приравнять Интернет к СМИ
 webplanet.ru
webplanet.ru
Неподдельное восхищение вызывает борьба члена Совета Федерации Владимира Иосифовича Слуцкера с беззаконьем в Интернете. В первый раз господин Слуцкер выступил на эту тему в феврале, заявив, что к обязательной регистрации в качестве средства массовой информации планируется привлечь владельцев всех са...
отметили
58
человек
в архиве
Кризис дошел до интернета? РБК сократил 5% своих сотрудников — более 100 человек
 kommersant.ru
kommersant.ru
РБК первым из российских медиакомпаний отреагировал на финансовый кризис. Компания сократила 5% своих сотрудников — более 100 человек — и затраты на некоторые проекты, в том числе на онлайн-службы и журнал Autonews.
отметили
93
человека
в архиве
Черногория введет безвизовый режим для граждан РФ
 rian.ru
rian.ru
Россия и Черногория подписали соглашение, которое по существу вводит безвизовый режим между двумя странами, сообщает МИД РФ по итогам встречи в среду в Нью-Йорке министра иностранных дел Сергея Лаврова с его черногорским коллегой Миланом Роченом.
проблема (1)
отметили
62
человека
в архиве
Маккейн решил приостановить предвыборную кампанию
 lenta.ru
lenta.ru
Кандидат в президенты США от республиканцев Джон Маккейн в среду объявил, что решил приостановить предвыборную кампанию и вернуться в Вашингтон в связи с финансовым кризисом в стране, передает агентство France Presse.
Маккейн проинформировал об этом решении своего соперника демократа Барака...
отметили
64
человека
в архиве
Сомалийские пираты напали на танкер ВМС США
 vesti.ru
vesti.ru
Сомалийские пираты атаковали танкер военно-морских сил США. Американцы отбились, открыв прицельный огонь из автоматов.
По словам представителя американских ВМС в регионе Стива Келли, танкер "Джон Лентхол" обычно доставляет топливо для военных кораблей, находящихся в Бахрейне. Инци...
отметили
56
человек
в архиве
На территории бывшего нацистского концлагеря Саласпилс в Латвии ставят памятник немецким солдатам
 ves.lv
ves.lv
Начало стройке положили отставные военные германского бундесвера (надо полагать, не без ведома городской администрации). В роще, где до этого отдыхали во время памятных мероприятий бывшие узники концлагеря и ветераны-освободители, теперь возведут каменную стену и монументальный крест в память о поги...
отметили
88
человек
в архиве
Телеканалу "2x2" продлили лицензию
 vesti.ru
vesti.ru
Федеральная конкурсная комиссия по телерадиовещанию рекомендовала продлить лицензию телеканалу "2х2", таким образом, поставив точку в скандальной ситуации вокруг канала.
Как сообщили ИТАР-ТАСС в пресс-службе телеканала, "члены ФКК приняли следующие решения: рекомендовать Феде...
проблема (4)
отметили
107
человек
в архиве
В Москве убит один из братьев Ямадаевых
 lenta.ru
lenta.ru
В центре Москвы был застрелен один из братьев Ямадаевых. По данным "Газеты.Ру", погиб Сулим Ямадаев; в ГУВД Москвы изданию сообщили, что именно он находился в машине Mercedes, обстрелянной 24 сентября возле дома номер 10 на Краснопресненской набережной. "Интерфакс" утверждает, чт...
проблема (1)
отметили
69
человек
в архиве
В НАТО убеждены: Москва усиленно шпионит за альянсом
 newsru.com
newsru.com
В НАТО убеждены, что Москва усиленно шпионит за альянсом. С момента начала конфликта в Грузии растет взаимное недоверие между Востоком и Западом. По миру поползли дикие слухи, пишет Financial Times (Deutschland).
По информации, которой располагает FTD, внутренние службы безопасности НАТО до...
проблема (1)
отметили
79
человек
в архиве
Москва может предложить Киеву строить авианосцы для ВМФ РФ
 rian.ru
rian.ru
Россия может предложить Украине задействовать ее судостроительные мощности для строительства авианосцев для ВМФ РФ, заявил РИА Новости в среду руководитель комиссии Совета Федерации по морской политике, бывший командующий Северным флотом адмирал Вячеслав Попов.
Так он прокомментировал заявл...
отметили
105
человек
в архиве
Посол США в Латвии: Советские ветераны заслуживают уважения
 rosbalt.ru
rosbalt.ru
Посол США в Латвии Чарльз Ларсон уверен, что к ветеранам антигитлеровской коалиции нужно относится с особым уважением. Об этом он заявил в интервью газете «Час».
«Это была великая война, в которой Россия, Соединенные Штаты, Великобритания и другие страны пошли на большие жертвы, чтобы побед...
проблема (2)
отметили
90
человек
в архиве
Sueddeutsche Zeitung: по карте Крым принадлежит Украине, а по факту - Москве
 inopressa.ru
inopressa.ru
Несмотря на то, что Крым принадлежит Украине, Киев имеет в родном порту российского Черноморского флота мало влияния. Выплачивая около 100 млн долларов в год, Россия взяла в аренду большую часть крымского портового города Севастополь.
Огромная территория с сотнями зданий, над которыми тепер...
отметили
84
человека
в архиве
Украина готова отдать газовый долг одним платежом
 top.rbc.ru
top.rbc.ru
Украина проинформировала Россию о намерениях вернуть одним платежом долг за газ прошлых лет, который в настоящее время погашается в счет платы за пребывание Черноморского флота в Крыму.
проблема (3)
отметили
95
человек
в архиве
Японские ученые научились уничтожать раковую клетку
 rian.ru
rian.ru
Ученые научно-исследовательского института индустрии и технологии и университета охраны здоровья и гигиены совместно разработали способ уничтожения раковой клетки в течение 10 дней, сообщил в среду представитель университета.
По его словам, для повышения эффективности световосприимчивого ле...
отметили
97
человек
в архиве
Продовольствие в России дорожает в четыре раза быстрее, чем в Европе
 newsru.com
newsru.com
Основные продукты питания – хлеб, мясо, масло, сахар, рыба и овощи – подорожали в России с начала года в 4 раза больше, чем в Евросоюзе. Такую неприятную статистику цен на продовольствие во вторник опубликовал Росстат. Эксперты объясняют аномальную продовольственную инфляцию отсутствием конкуренции ...
отметили
67
человек
в архиве
Солнечная система теряет свою защиту - ученые
 cybersecurity.ru
cybersecurity.ru
Как сообщили в Европейском космическом агентстве, космический аппарат Улисс, работавший минувшим летом в непосредственной близости от Солнца, показал, что наше светило сократило выбросы вещества солнечного ветра до минимальных объемов за все время наблюдения. Всего подобные наблюдения за Солнцем вед...
отметили
83
человека
в архиве
Financial Times: Европейцы не хотят спасать страны Балтии от России в случае военной агрессии
 biznews.lv
biznews.lv
Большинство жителей стран Западной Европы возражает против отправки своих вооруженных сил в страны Балтии в случае военной агрессии со стороны России.
Об этом свидетельствуют результаты опроса проведенного газетой Financial Times, сообщает портал diena.lv. Несмотря на имеющийся в уставе НАТ...